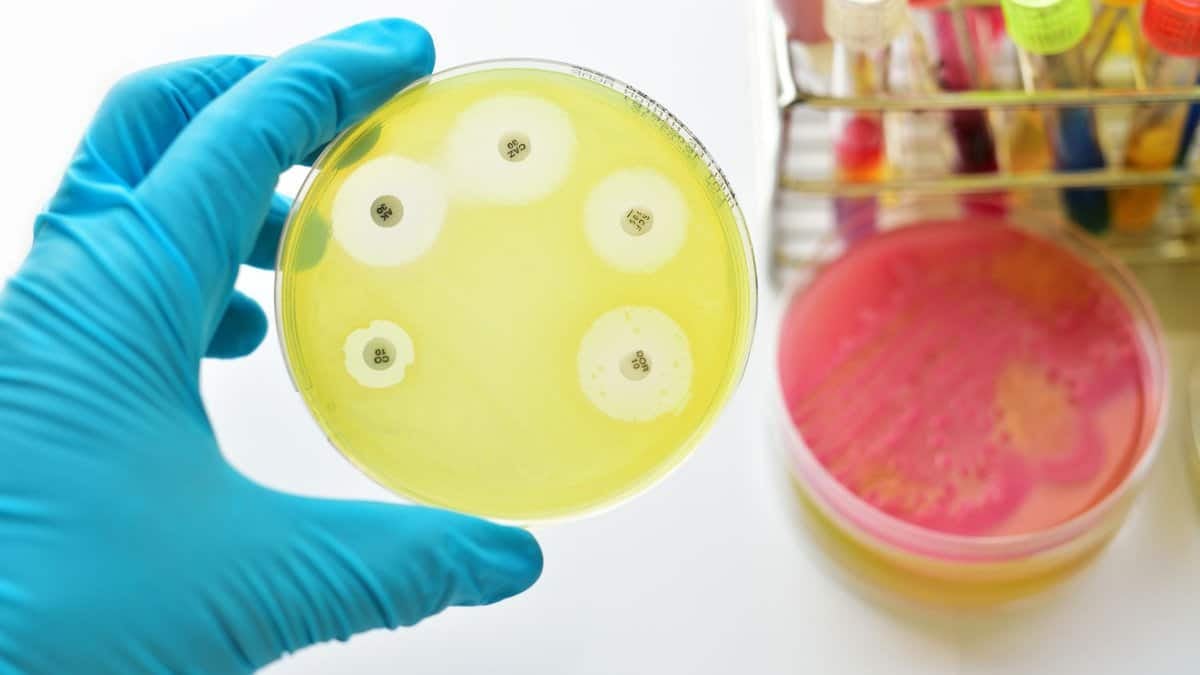
img-5

Ная гаруй жилийн өмнө хүн төрөлхтөн пенициллинийг өргөн дэлгэр ашиглаж эхэлснээр бактери нь антибиотик эмчилгээнээс “зугтах” аргаа хайж эхэлсэн юм. Тэр цагаас хойш аюултай бактери болон хүмүүсийн хооронд дайн дэгдсэн агаад ихэнх талбарт хүмүүс ялагдсаар буйг сүүлийн судалгаанууд харуулж байна.
“Антибиотикт тэсвэртэй бактерийн тоо аажмаар өссөөр тахлын түвшинд хүрээд байгааг хүн төрөлхтөн бараг л анзааралгүй явж ирлээ. Гэвч ийм бактери эрс нэмэгдэхийн хэрээр тэдгээрийг дарах шинэ антибиотик дутагдах болсон учир энэ байдлыг яаралтай өөрчлөх ёстой” гэж АНУ-ын Эрүүл мэндийн үндэсний хүрээлэнгийн (ЭМҮХ) харьяа Харшил, халдварт өвчин судлалын үндэсний институтийн судлаач Кристина Ек анхааруулж байна.
Зарим бактери антибиотикт тэсвэртэй болсон нь дэлхийн эрүүл мэндийн салбарын хамгийн том сорилтуудын нэг болоод байгаа талаар Дэлхийн эрүүл мэндийн байгууллага мэдэгдсэн. Ийм бактерууд нь жил тутам таван сая орчим хүний амь насийг авч оддог аж. АНУ-д гэхэд нэг жилд антибиотикт тэсвэртэй бактерийн халдвар туссан 2.8 сая тохиолдол бүртгэгддэг агаад ихэнх нь эмнэлгээс ийм халдвар авсан байдаг. Хэрэв тухайн бактери антибиотикт дийлддэггүй бол өвчтөнийг эмчлэх маш хэцүү болно.
“Үр дүнтэй антибиотик огт байхаа больсон антибиотикгүй эриний талаар бид өмнө нь ярьдаг байсан бол тийм үе нэгэнт ирснийг маш олон баримт харуулж байна.
Хэрэв антибиотик байхгүй бол өвчтөний эмчилгээний үр дүн маш харуусам болно. Нас барна, халдвартай удаан хугацаанд явна, эмнэлэгт удаан хэвтэж эмчлүүлнэ гэх мэт” гэж Йелийн Анагаахын сургуулийн халдварт өвчний эмч, тус сургуулийн Халдварт өвчнөөс сэргийлэх хөтөлбөрийн эмчилгээ хариуцсан захирал Рик Мартинелло хэлсэн.
Карбапенам гэж нэрлэдэг антибиотикт тэсвэртэй микробуудын тоо хамгийн ихээр нэмэгджээ. Acinetobacter baumannii, Pseudomonas aeruginosa, Enterobacterales зэрэг бактери нь антибиотикт ихээхэн тэсвэртэйг судалгаанууд харуулсан. Антибиотикт тэсвэртэй микробын халдвараар 29400 хүн нас барсан 2020 онд буюу КОВИД-19 цар тахлын үеэр анхны сэрэмжлүүлгийг Өвчний хяналтын төв гаргаж байлаа. Эдгээр халдварын бараг тал хувийг өвчтөнүүд эмнэлэгт эмчлүүлж байхдаа авчээ. Цар тахлын дараа энэ хэмжээ буурна гэсэн найдвар байсан ч эмнэлгээс халдвар авах хэмжээ буурахгүй хэвээр байна.
Гэтэл ийм халдварыг эмчлэх эмийн тоо энэ өсөлттэй ижил хурдаар нэмэгдэхгүй байгаа юм. Сүүлийн жилүүдэд АНУ-ын Хүнс, эмийн байгууллагын батламжилсан ихэнх шинэ антибиотик нь өмнөх эмүүдийн хувилбарууд байсан агаад тэсвэртэй микробыг онилсон шинэ эмчилгээ болж чадахгүй байгаа юм. “Хүмүүс энэ талбарт зогсонги байдалд орсон бол эмэнд тэсвэртэй бактеруудын тоо нэмэгдсээр байна” гэж К.Ек өгүүлсэн.
Даатгалын компаниуд болон эрүүл мэндийн системийн хоёр сая өгөгдлийг ЭМҮХ судалсан байна. Тэд мөн уг халдварт хамгийн их өртөж буй бүлгүүдийг тодорхойлохыг зорьжээ.
Архаг өвчинтэй, эсвэл өвчин нь хүндэрсэн хүмүүс ийм төрлийн халдвар илүү их авдаг. Түүнчлэн испани гаралтай америкчууд, орлогын болон боловсролын түвшин доогуур хүмүүсийн халдварт өртөх эрсдэл ч их байгаа юм. “Нийгмийн эмзэг давхаргын хүмүүс илүү их эрсдэл дунд байгаа нь бидний цуглуулсан өгөгдлөөс харагдлаа” гэж К.Ек онцолсон.
Ийм төрлийн бактерийн халдварыг хаанаас авч байгаа нь санаа зовоосон асуудал боловч эмнэлгээс авсан халдвар нь илүү ноцтой үр дагавар дагуулдаг аж.
Учир нь ийм төрлийн бактери нь илүү халдварлах чанартай, маш олон төрлийн антибиотикт тэсвэртэй байдаг учраас хүнийг үхэлд хүргэх, хөгжлийн бэрхшээлтэй болгох илүү өндөр магадлалыг тээж байдаг юм.
“Бид нар хүмүүсийг ийм байдалд оруулдаг тал бий” гэж К.Ек нэмж хэлсэн. Учир нь гуурс, уян зүү, мэс заслын зүсэлт зэргээр өвчтөний биед “нэвтэрдэг” эрх эмч нарт л бий билээ.
Антибиотикийн замбараагүй, хэт их хэрэглээний улмаас антибиотик тэсвэржилт бий болдог гэдгийг эрдэмтэд тогтоосон ч энэ ойлголт байдлыг өөрчилсөнгүй. Эрүүл мэндийн салбараас гадна мал эмнэлэг, хөдөө аж ахуйн салбарт антибиотикийг маш ихээр хэрэглэж байна. “Антибиотикийг тахиа, үхрийг таргалуулах, түргэн өсгөх зорилгоор ашиглах боломжтой. Мөн тоор, алимны модонд антибиотик цацдаг” гэж Р.Мартинелло хэлэв.
Антибиотик хэрэглэх үед хүний бие дэх маш олон бактери, мөөгөнцөр үхдэг ч тэсвэр сайтай нь амьд үлдээд зогсохгүй үржиж, тэсвэрлэх чадвараа бусад организмд тараадаг байна. Улмаар цаг хугацааны туршид зарим бактери зөвхөн нэг төдийгүй нэлээд хэдэн антибиотик тэсвэрлэхүйц болдог. Олон төрлийн эмэнд тэсвэртэй ийм микробуудыг эмчлэх нь тун амаргүй юм.
Ийм нөхцөлд эмийн харилцан нөлөөг эрчимжүүлэх зорилгоор олон төрлийн антибиотик хэрэглэдэг. Гэвч ихэнх тохиолдолд “халдвар авсан өвчтөн бүрэн эмчлэгддэггүй агаад халдварын улмаас амиа алдах нь дийлэнх байдаг” гэж К.Ек анхааруулав. Эмийг хольж хэрэглэх нь зарим өвчтөний эмчилгээнд үр дүнтэй байдаг. Тухайлбал авибактамыг сефтазидимтэй хослуулж хэрэглэснээр P.aeruginosa-ийн эсрэг эмчилгээний үр нөлөө 65 хувиас 94 хувь болж нэмэгддэг аж.
Эрдэмтэд үр дүнтэй, шинэ эмийн эрлээ үргэлжлүүлсээр байна. Антибиотикийн шинэ төрлийг бий болгох магадлалтай бактерийн зарим энзимд нөлөөлөх шинэ аргыг саяхан Массачусетсийн технологийн их сургуулийн судлаачид нээсэн. Зарим эрдэмтэн шинэ эмчилгээ олохын тулд хиймэл оюуныг ашиглаж байна.
Харин тэр хүртэл эмнэлгүүд бактерийн халдварыг бууруулах зорилгоор тусгай дүрэм, журам гарган ашиглах нь үр дүнтэй байх боломжтой. Үүнд гараа угаах, эмнэлгийн хэрэгслийг ариутгах, цэвэрлэгээг сайжруулах зэрэг арга хэмжээ багтана. Мөн хэвтэж эмчлүүлэх хугацаанд антибиотик хэрэглэх хугацааг аль болох бууруулахыг судлаач нар зөвлөж эхэлсэн. Антибиотикийн хэрэглээг бууруулснаар нас барах эрсдэлийг нэмэгдүүлэлгүйгээр хэвтэн эмчлүүлэх хоногийг багасгаж болно.
Түүнчлэн заримдаа өвчтөнүүдийн санааг амраахын тулд антибиотик бичиж өгдөг аргаас өрхийн эмч нар татгалзах нь зүйтэй хэмээн К.Ек сануулж байна. “Антибиотик нь цаг үргэлж зөв шийдэл байх боломжгүй. Хамрын хөндийн архаг үрэвсэл нь харшлаас, ханиад нь вирусаас шалтгаалдаг. Ийм нөхцөлд антибиотик огтхон ч тус болохгүй. Хэрэв бактерийн халдвар авсан үед эмч олон микробын эсрэг үйлчилгээтэй антибиотик бичиж өгвөл тухайн өвчинд илүү тохирсон, үр дүнтэй өөр эм байгаа эсэхийг лавлаарай” хэмээн тэрбээр зөвлөж байна.
Мөн антибиотикийн агууламж бага органик хүнс худалдаж авахыг хэрэглэгчдэд, хөдөө аж ахуй, мал аж ахуйн салбарт антибиотик ашиглахаа багасгахыг хүнс үйлдвэрлэлийн компаниудад Р.Мартинелло уриалжээ. “Бид антибиотикийн талаарх ойлголтоо шинэчлэх ёстой. Хэрэв буруу хэрэглэвэл үр нөлөө, ач тус нь буруугаар эргэх, эсвэл ямар ч үр дүнгүй байх боломжтой гэдгийг хүмүүс ч, үйлдвэрлэгчид ч ойлгох цаг нь иржээ” хэмээн тэрбээр өгүүлж байна.
Нийтлэлийг Мерил Дэвидс Ландау
Эх сурвалж: national geographic